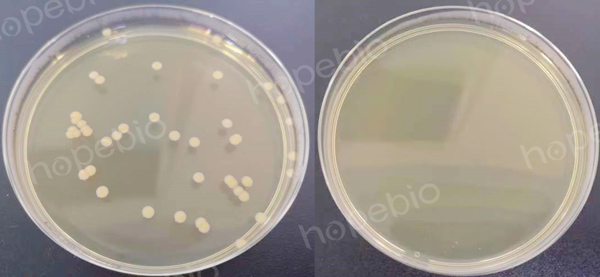
（左）菌数为39CFU，实验组2（右）无菌生长
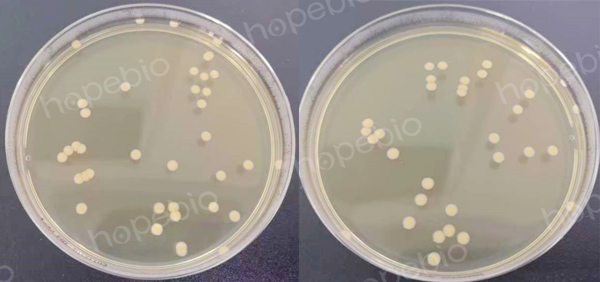
（左）菌数为38CFU，实验组4（右）菌数为32CFU

海博微信公众号
海博微信公众号
 海博天猫旗舰店
海博天猫旗舰店


 海博微信公众号
海博微信公众号
 海博天猫旗舰店
海博天猫旗舰店




一、培养基的应用
GMP生产车间进行沉降菌检测时,有些环境下会残留抗生素类抑菌成分,污染至测沉降菌的平板上,对沉降菌的生长产生抑制效果,导致监测结果不准确。因此,对此类环境沉降菌进行监测时,通常使用加入相应的酶类TSA平板,以消除残留的抗生素的影响。
二、验证方法
进行方法验证之前,首先要确认沉降菌的每皿抗生素残留量最大值为多少,验证时可按照此最大值的120%浓度进行测试。
例:某车间测定沉降菌时,9cm平皿测试沉降菌时,残留的青霉素最大量为0.5mg/皿,现有含青霉素酶的TSA平皿(每皿含青霉素酶2万单位),测定此平皿是否能消除残留的青霉素的影响。
试验方法:
(1)选用金黄色葡萄球菌为测试菌株,活化后用生理盐水梯度稀释至适宜浓度;
(2)将青霉素的标准样品稀释至适宜浓度,过滤除菌;
(3)制成编号1和2含金黄色葡萄球菌浓度相同的菌悬液(含菌量为10-100CFU/mL),2号菌悬液同时含青霉素6mg/mL;
(4)准备4组平板,1组为正常的TSA平板(对照组),涂布编号1的菌液0.1mL,2组为正常的TSA平板,涂布编号2的菌液0.1mL,3组为含酶的TSA平板,涂布编号1的菌液0.1mL,4组为含酶的TSA平板,涂布编号2的菌液0.1mL,将接种后的平板置35℃培养24-48h,计数。
试验组1(左)菌数为39CFU,实验组2(右)无菌生长
试验组3(左)菌数为38CFU,实验组4(右)菌数为32CFU
结果分析:
1组生长良好,2组无菌生长,说明加入的抗生素是有效的,3组与1组相比,菌数一致,说明含酶的培养基本身是合格的,没有抑菌性,4组与1组相比,菌数基本一致(比值在0.5-2之间),说明培养基中的酶可消除0.6mg/皿的青霉素的抑菌效果。
试验其他结果分析及改进:
(1)若试验组2出现部分菌落生长,说明抗生素抑菌效果不高或者该菌对此抗生素效果不够敏感,可以扩大测试菌株范围或使用敏感菌株;
(2)若试验组3的菌数比试验组1明显偏少,可能培养基的质量存在问题。在确认培养基的质量没有问题的情况下,试验组1和3只做一组即可做为对照;
(3)若试验4组菌数明显偏少或不生长,说明培养基并没有消除抗生素的抑制效果,需加大酶的用量或选用其他合适的酶进行测试。
注:本文属海博生物原创,未经允许不得转载。
下一篇:两种β-半乳糖苷酶的测定方法
| 相关文章: |



